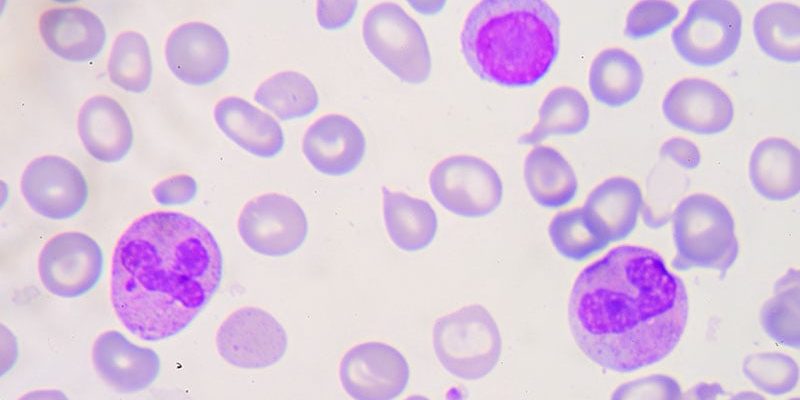
CRISPR-basierte Gentherapie erhält Zulassung für Beta-Thalassämie

Bildnachweis: CC0 Public Domain Gesetzesänderungen im Vereinigten Königreich stellen eine Bedrohung für die Sicherheit von Messaging-Apps dar – und damit für deren Verwendung im NHS. ...
READ MORE +
Bildnachweis: CC0 Public Domain Gesetzesänderungen im Vereinigten Königreich stellen eine Bedrohung für die Sicherheit von Messaging-Apps dar – und damit für deren Verwendung im NHS. ...
READ MORE +
Der Kapitän der indischen Fußballmannschaft, Sunil Chhetri, hat sowohl Lionel Messi als auch Kylian Mbappe bei seiner Abstimmung für die Auszeichnung „Bester Spieler der FIFA 2023“ abgelehnt. Am Ende gewann die argentinische Ikone die Auszeichnung punktgleich mit Manchester Citys Superstar ...
READ MORE +
Die US-amerikanische Food and Drug Administration (FDA) hat die auf CRISPR-Geneditierung basierende Therapie Exagamglogene Autotemcel oder Exa-Cel (Casgevy) von Vertex Pharmaceuticals für Personen ab 12 Jahren mit transfusionsabhängiger Beta-Thalassämie, einer seltenen vererbten Blutkrankheit, ...
READ MORE +
Der Kalender hat den Februar noch nicht erreicht, aber der Indiana Pacers haben beschlossen, die Handelsfrist auf Hochtouren zu bringen. Die Nummer 6 der Eastern Conference machte einen Win-Now-Zug, da der Darkhorse-MVP-Kandidat Tyrese Haliburton derzeit wegen einer Oberschenkelverletzung ...
READ MORE +
Einleitung: Emetophobie, Würgen und Zahnarztangst In einer kürzlich veröffentlichten Studie in der Internationales DentaljournalForscher untersuchten den möglichen Zusammenhang zwischen selbstberichteter Emetophobie, übermäßigem Würgen und Angst in der Zahnarztpraxis. Zahnarztangst ...
READ MORE +
Luis Castro, Trainer von Al Nassr, erklärte kürzlich, dass es Cristiano Ronaldo nicht gut ging, bevor er zu Al Nassr wechselte. Er behauptete, dass der Fußballer viel durchgemacht habe – auf und neben dem Spielfeld – und dass dies dazu geführt habe, dass seine Form nachgelassen habe. In ...
READ MORE +
Bildnachweis: Pixabay/CC0 Public Domain Die routinemäßige Überweisung von Patienten an ein maßgeschneidertes Physiotherapieprogramm nach einer Schulterluxation ist nicht besser als ...
READ MORE +
Die Buffalo Bills sind die Größten Was-wäre-wenn-Franchise in der NFL-Geschichte. Sie haben immer wieder Großes erlebt, ohne dass es auf sie abfärbte. Nächsten Monat nähert sich Buffalo dem 30. Jahrestag der vierten Super Bowl-Niederlage von Marv Levys K-Gun Bills. Die Bills oder Chiefs werden ...
READ MORE +
Die Food and Drug Administration hat das DermaSensor-Gerät für nicht-invasive Point-of-Care-Tests für alle Arten von Hautkrebs zugelassen.Das kabellose Handgerät, das von DermaSensor Inc. mit Sitz in Miami entwickelt wurde, arbeitet mit Batteriestrom, nutzt Spektroskopie und Algorithmen, um ...
READ MORE +
Jamal Murray konnte bei der 126:121-Auswärtsniederlage der Denver Nuggets gegen die Philadelphia 76ers am Dienstag nur 17 Punkte erzielen. „Glitch“, der sein Team letztes Jahr in den Playoffs fest im Griff hatte, kämpfte besonders im vierten Viertel. Der Startpunktwächter von Denver verfehlte ...
READ MORE +